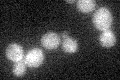
YPR009W
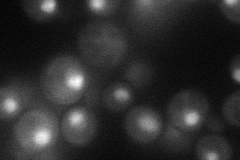
YPR009W
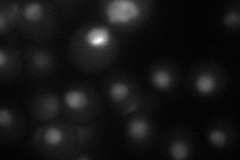
YPR009W
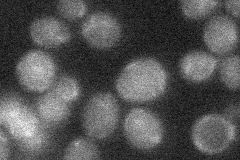
YPR009W
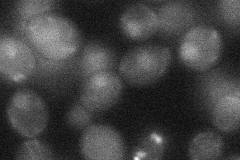
YPR009W
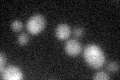
YPR009W

View description
Putative transcription factor; multicopy suppressor of mutations that cause low activity of the cAMP/protein kinase A pathway; highly similar to Sut1p
Localization:
Intensity:
Fold change:
Significance:
-
C’ GFP library in SD
below threshold16.24 -
N' NOP1pr-GFP in SD
nucleus44.5903 -
N' TEF2pr-mCherry in SD
nucleus22.0581 -
N' NATIVEpr-GFP in SD
below threshold21.1829 -
N' TEF2pr-VC and Cyto-VN in SD
nucleus27.131 -
C’ GFP library in SD+DTT
cytosol16.861.03No -
C’ GFP library in SD+H2O2

cytosol17.221.05No -
C’ GFP library in Starvation Media

cytosol16.481.01No -
C’ GFP library on the background of Pup2-DaMP

below threshold -
C’ GFP library on the background of CCT mutant

below threshold16.86531.03791No
